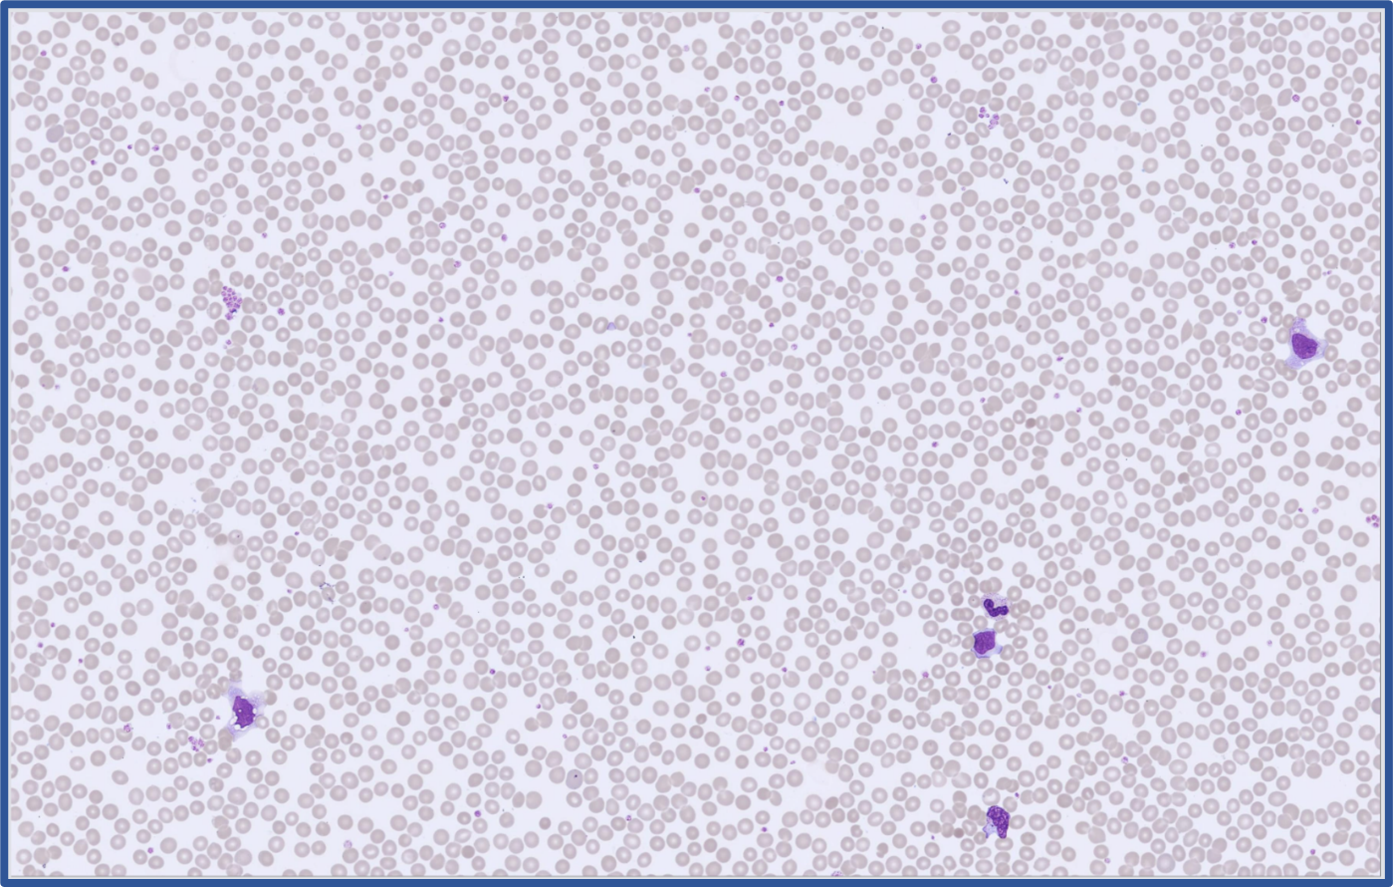
Global Test 2026:1 RBC Overview

CellaVision Global Test 2026:1 – Infectious Mononucleosis
Case Description
A 19-year-old man was seen in a primary care clinic with a 2-week history of: persistent fatigue, intermittent low-grade fever, mild sore throat, tender posterior cervical lymph nodes, upper left abdominal fullness and reduced appetite.
Laboratory Findings
Complete blood count (CBC):
|
Test |
Result |
Reference Interval (male) |
Unit |
|
WBC |
13.97 |
4.0 - 10.0 |
x109/L |
|
RBC |
4.57 |
4.5 – 5.9 |
x109/L |
|
HGB |
13.7 |
13.5 – 17.5 | g/dL |
|
HCT |
39.7 |
41 – 53 |
% |
| MCV | 86.9 | 80 - 100 | fL |
| MCH | 30.0 | 27 - 33 | pg |
| MCHC | 34.5 | 32 - 36 | g/dL |
| PLT | 116 | 150 – 400 | x109/L |
| RDW | 12.5 | 11.5 - 14.5 | % |
Cell Counter Differential:
|
Test |
Result (x109/L) |
Unit (%) |
|
Neutrophils |
2.26 |
16.2 |
|
Lymphocytes |
--- |
--- |
|
Monocytes |
--- |
--- |
|
Eosinophils |
0.07 |
0.5 |
| Basophils | 0.05 | 0.4 |
| IG | 0.13 | 0.9 |
| NRBC | 0.0 | 0.0 |
WBC flags: WBC Abnormal Scattergram, Monocytosis, Blasts/Abnormal Lymphocytes?
Analysis Details
Stain: May–Grünwald–Giemsa
Analyzer: CellaVision DC-1, CDMS 7.2, LED Microscope mode
Sample of cells classified in the Global Test 2026:1

RBC Overview
Case conclusion
Laboratory testing showed a slight leukocytosis (WBC 13.97 ×10⁹/L) and thrombocytopenia (PLT 116 ×10⁹/L). The automated differential was partially unreliable where the lymphocyte population was not reported due to an abnormal scattergram. Analyzer flags indicated abnormal WBC scattergram, monocytosis and possible abnormal/atypical lymphocytes or blasts. Peripheral blood smear examination showed slightly increased WBC count with lymphocytosis with approximately 50% reactive lymphocytes with characteristic dark blue cytoplasm and irregular nuclear shape. Normal hemoglobin and RBC count and a decreased PLT count with PLT clumps present.
Diagnosis
Infectious Mononucleosis
Global Test 2026:1 Results Webinar
- Case presentation
- DC-1 Analysis - the WBC differential and RBC Characterization
- Differences in classification between examiner and participants
- Discussion about Mononucleosis – From symptoms to laboratory diagnosis